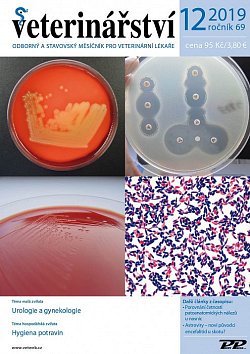

Archiv časopisu Veterinářství: ročník 2019

č. 1/2019
vyšlo 17.1.2019

č. 2/2019
vyšlo 14.2.2019

č. 3/2019
vyšlo 18.3.2019

č. 4/2019
vyšlo 9.4.2019

č. 5/2019
vyšlo 16.5.2019

č. 6/2019
vyšlo 17.6.2019

č. 7/2019
vyšlo 15.7.2019

č. 8/2019
vyšlo 16.8.2019

č. 9/2019
vyšlo 18.9.2019

č. 10/2019
vyšlo 17.10.2019

č. 11/2019
vyšlo 14.11.2019
č. 12/2019
vyšlo 11.12.2019